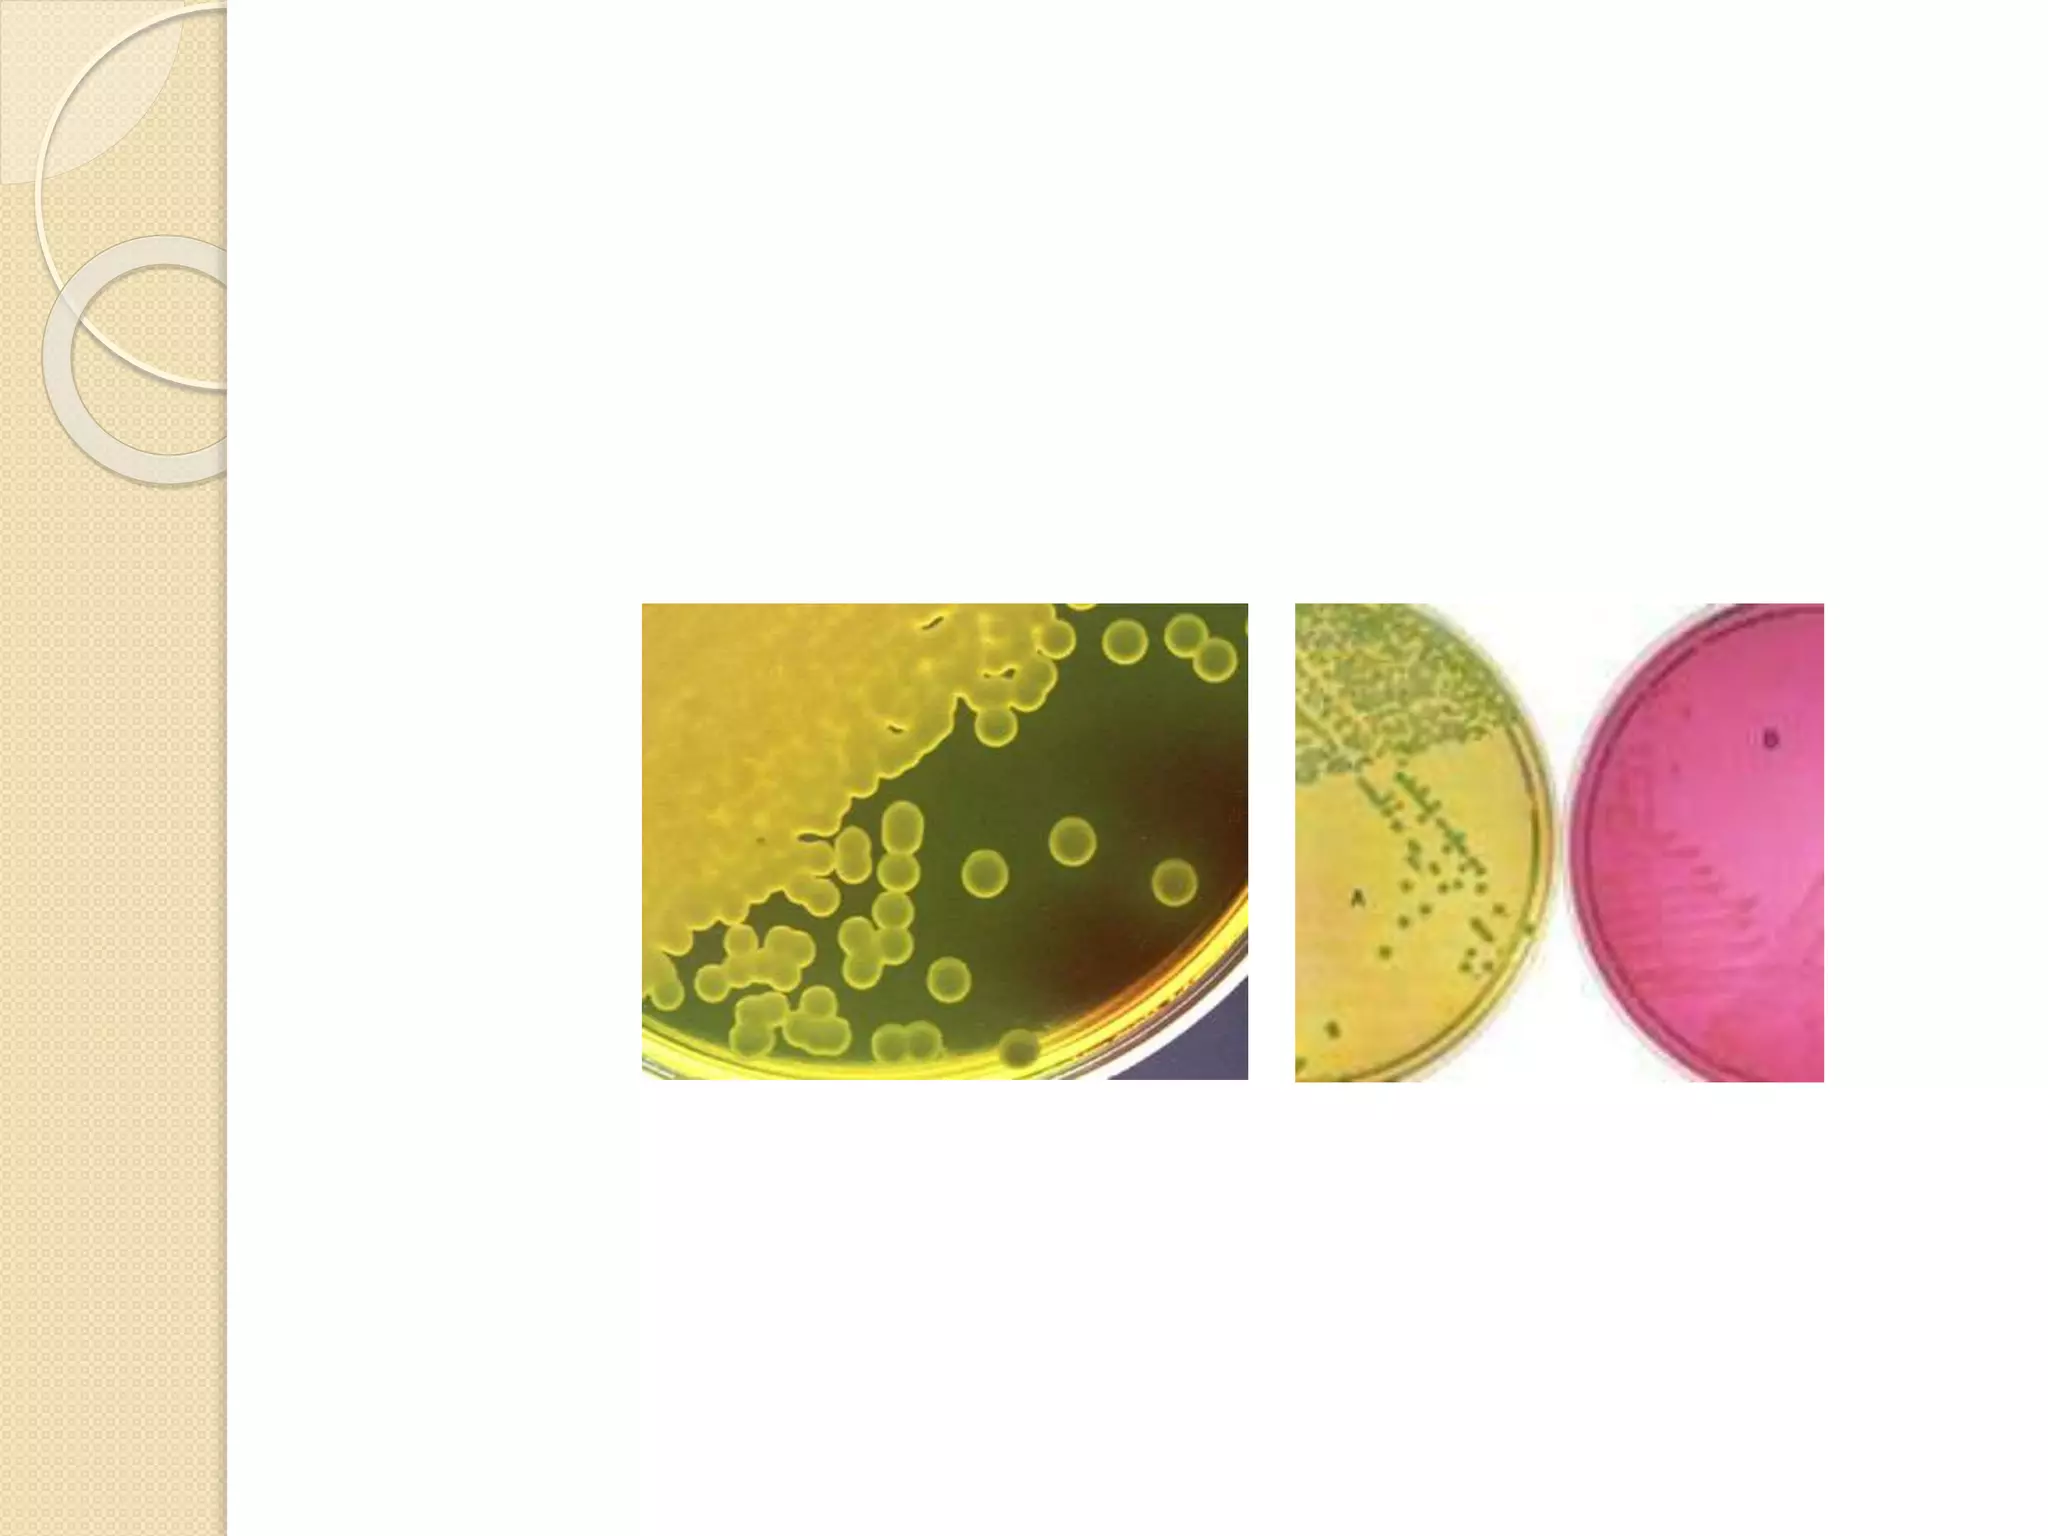
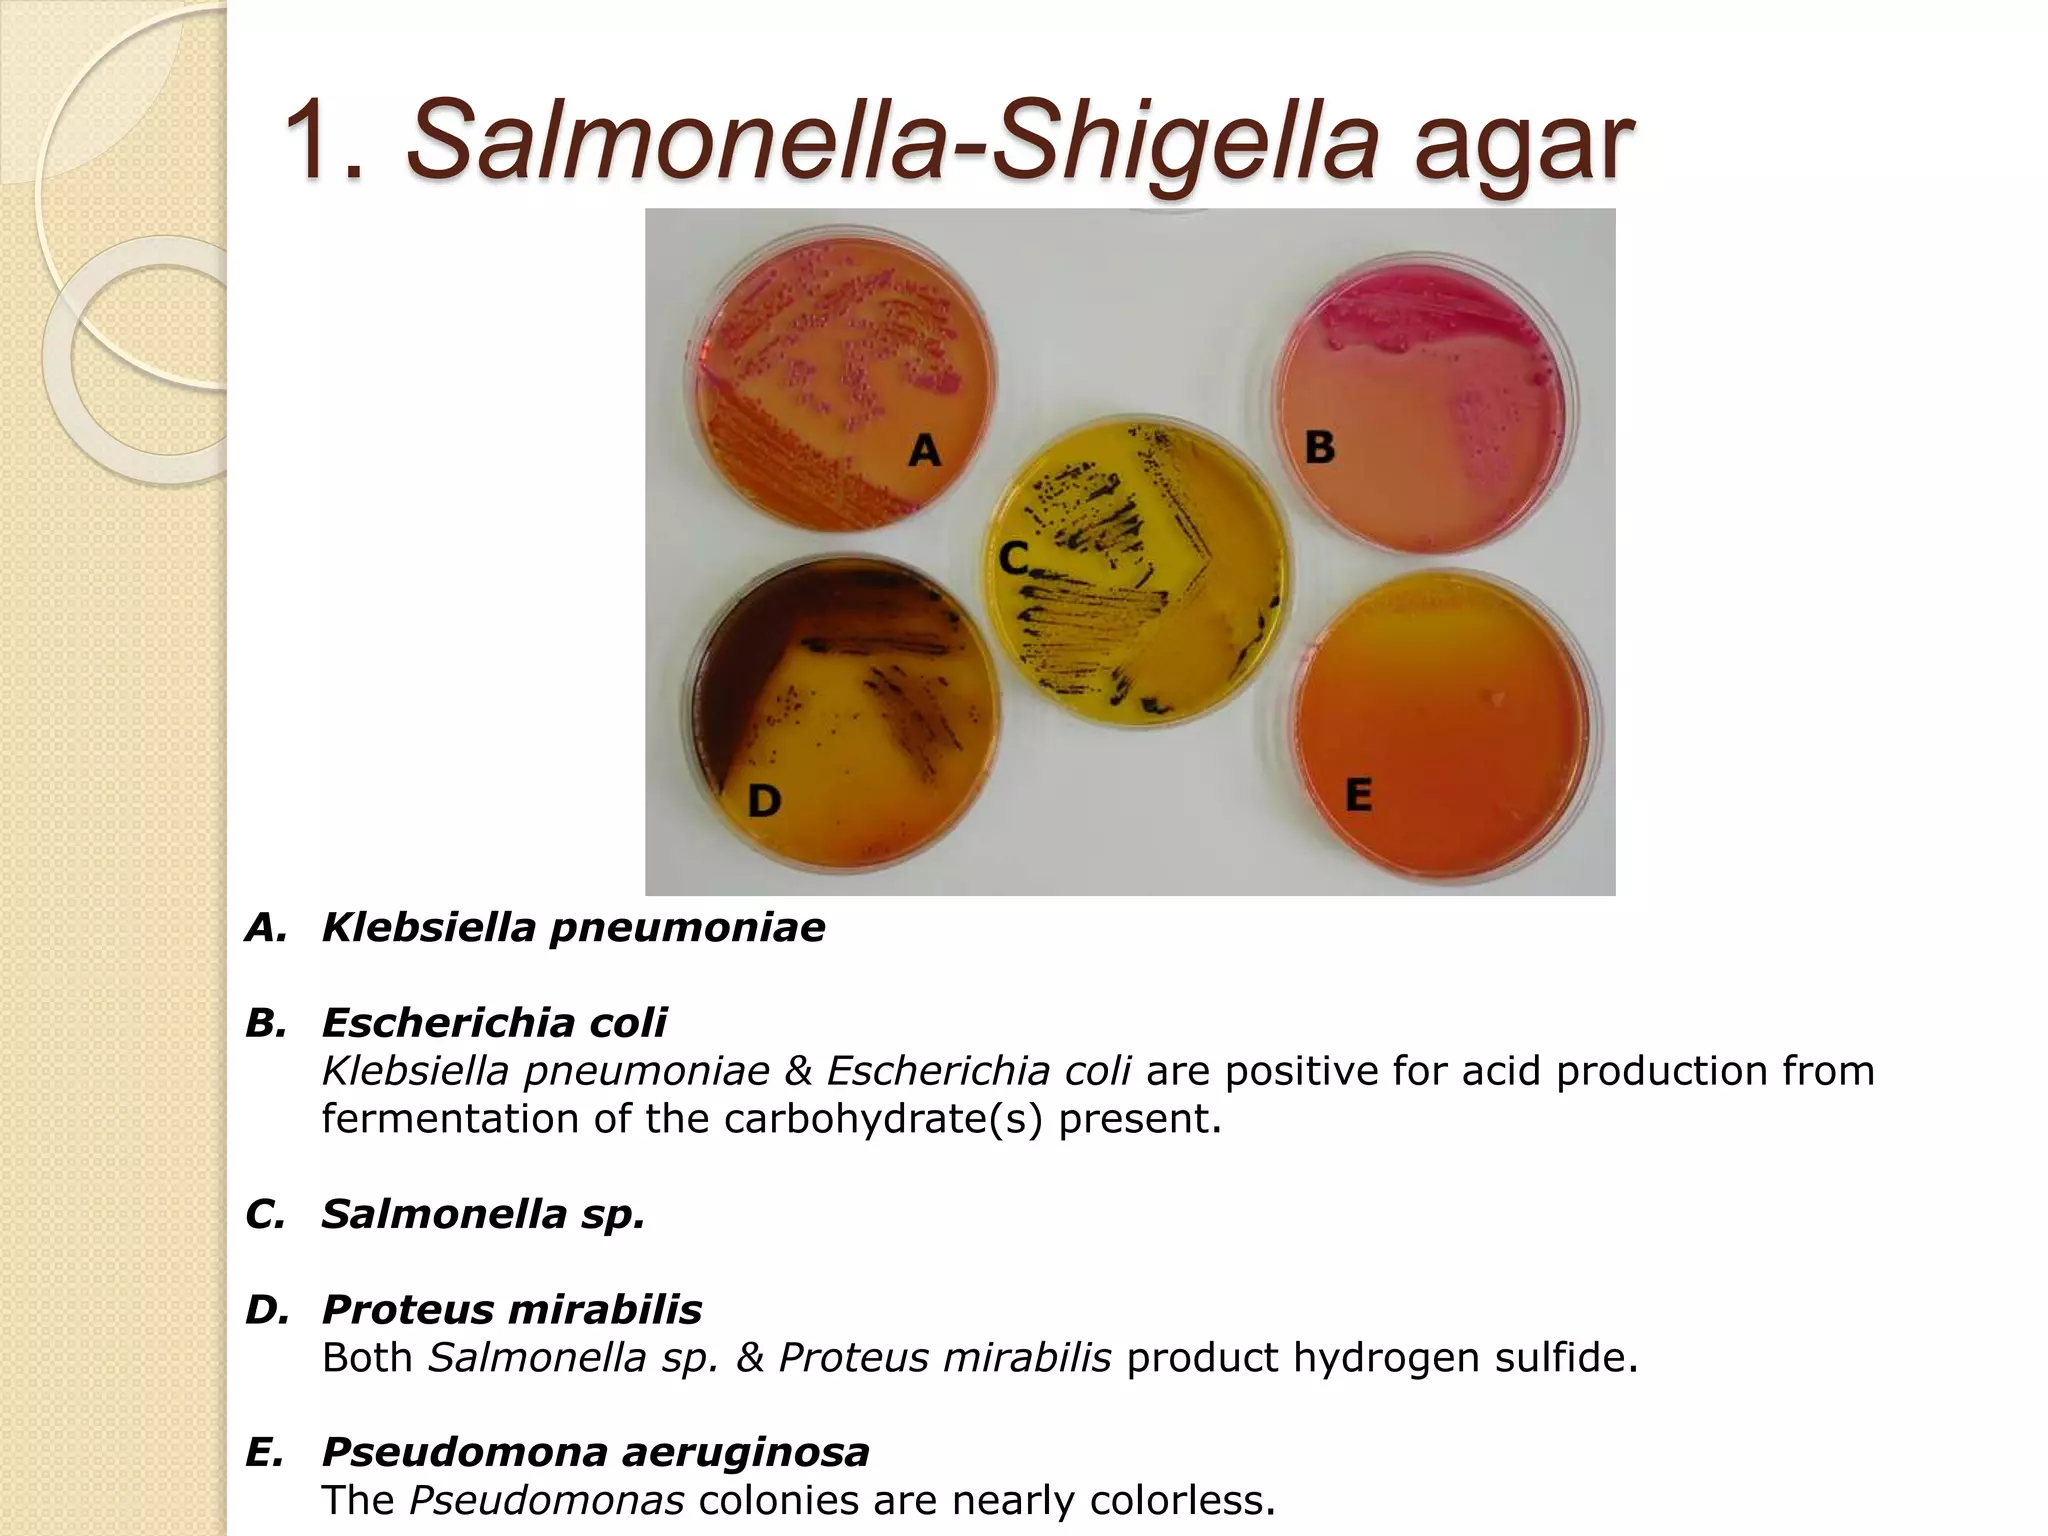
1. Salmonella-Shigella agar
A. Klebsiella pneumoniae
B. Escherichia coli
Klebsiella pneumoniae & Escherichia coli are positive for acid production from
fermentation of the carbohydrate(s) present.
C. Salmonella sp.
D. Proteus mirabilis
Both Salmonella sp. & Proteus mirabilis product hydrogen sulfide.
E. Pseudomona aeruginosa
The Pseudomonas colonies are nearly colorless.
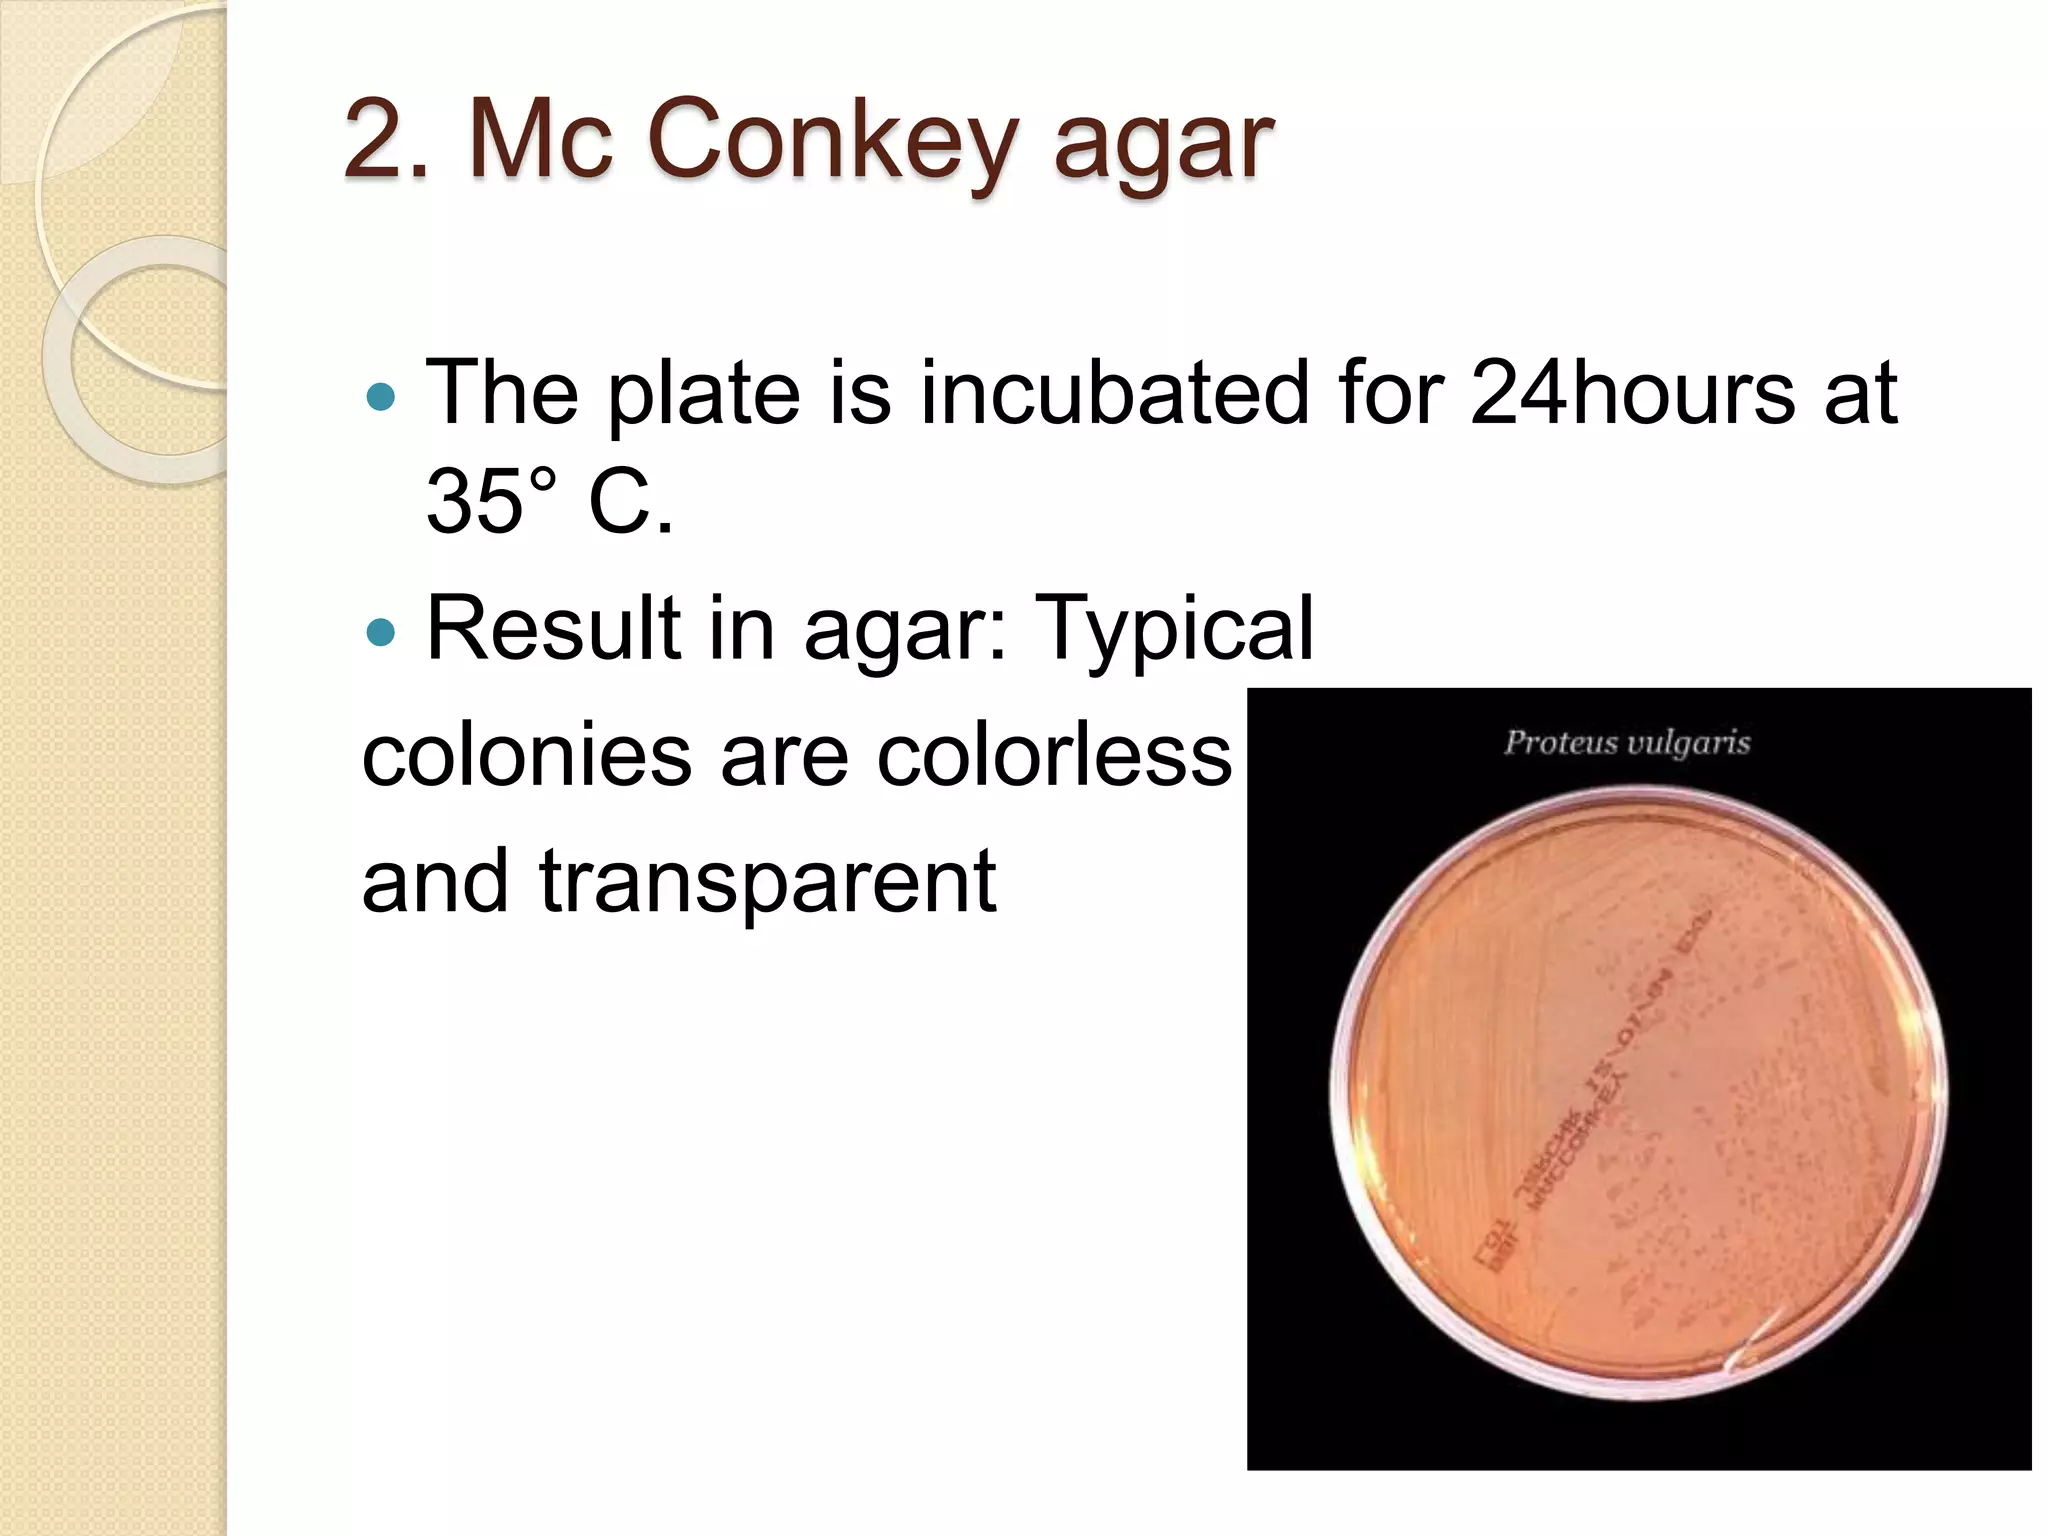
2. Mc Conkey agar
 The plate is incubated for 24hours at
35° C.
 Result in agar: Typical
colonies are colorless
and transparent

This document discusses various methods for enumerating and testing for microorganisms in food. It describes total plate counts, coliform tests, and tests for mesophilic bacteria, staphylococci, Salmonella, Shigella, and other pathogenic bacteria. Specific procedures are outlined, including enrichment, plating, screening, and confirmation steps. A variety of media are used, such as violet red bile agar, Baird-Parker agar, triple sugar iron agar, and lysine iron agar. Colonies are examined for characteristics like color, zone formation, and biochemical reactions to identify microorganisms.